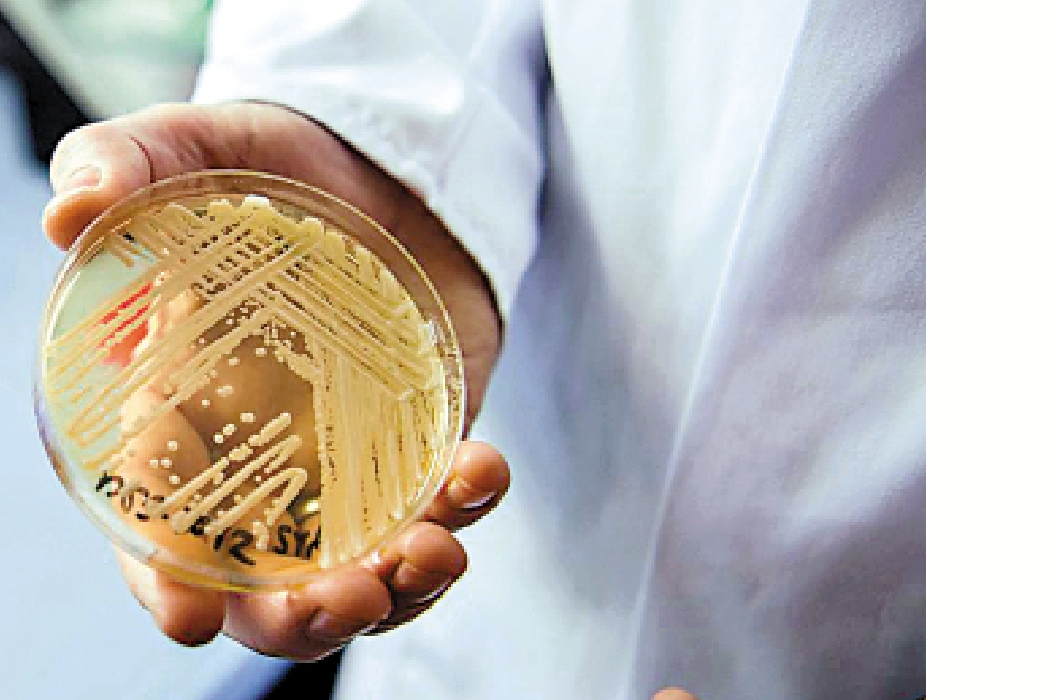

(大公報 記者 易曉彤)新冠疫情遠去,但傳染病威脅持續存在。可奪命的耳念珠菌在公立醫院今年已錄13宗,其中8宗近日在兩個病房發現,均是年長、無徵狀病人。
耳念珠菌現已攻陷半個美國,本港自2019年出現首宗感染以來,起碼有331宗個案,兩年間新增起碼127宗。公立醫院現已放寬探訪,專家提醒市民去醫院探病時,要注意手部消毒,防範感染措施不要鬆懈。
耳念珠菌的殺傷力不容低估,世界衞生組織去年10月公布的一份真菌清單上,耳念珠菌被認定為威脅級別最高的真菌之一。由於常用抗真菌藥物經常沒有效用,一旦受感染,將難以治療。有傳染病科專家表示,耳念珠菌對常用的抗真菌藥物如氟康唑、兩性黴素B、棘白菌素類的耐藥性,分別約90%、30%和少於5%。
在本港,九龍醫院前日公布,醫院內科延續護理男病房一名90歲男病人及康復科女病房一名74歲女病人,於3月21日確診感染耳念珠菌,但沒有感染徵狀。院方根據既定指引展開追蹤篩查,再發現多兩名曾經與該男病人入住同一病房,分別為76歲及77歲的男病人,以及4名曾與該女病人入住同一病房,分別為75歲及97歲的女病人帶有耳念珠菌,但並無感染徵狀。其中一名病人已出院,另外七名病人仍然留醫,現正接受隔離治療,情況穩定。
常進出醫院 易交叉感染
本港於2019年6月錄得首宗耳念珠菌個案,患者曾到瑞士旅遊;同年7月錄得第二宗個案,患者居住美國,由菲律賓經香港準備返美國途中,心臟病發,入院後發現帶有耳念珠菌。根據醫管局數字,截至2020年10月,本港累計有約160宗個案。大公報記者翻查醫管局透過政府新聞處發布的新聞稿,點算發現,由2020年11月至今,本港累計再增約127宗個案。
有專家指出,一般人在普通社區環境下較難受耳念珠菌感染,但本身如有長期病、經常進出醫院或住院人士就要留神,在醫院內更要提防病人之間的交叉感染。
感染及傳染病醫學會副會長林緯遜認為,本港雖早已出現耳念珠菌個案,公院感染數字基本上是局部時間出現大波動,可能是醫院篩查時「走漏」。醫管局若能做好感染控制措施和篩查,理論上能有效控制耳念珠菌爆發。
醫管局篩查高風險病人
醫管局回覆《大公報》查詢表示,一直關注耳念珠菌傳播情況,各公立醫院採取風險為本的策略,安排為有較高風險的住院病人進行耳念珠菌篩查。近期錄得的個案,均屬無感染徵狀帶菌者,亦沒有發現由耳念珠菌引起的入侵性感染病例。
醫管局發言人稱,已制定嚴格的感染控制指引,一旦發現有病人帶有耳念珠菌,會即時安排隔離治療,並對密切接觸者展開接觸追蹤調查,同時加強各項感染控制措施,包括徹底清潔及消毒有關病房,加強病人入院篩查及環境篩查,以及嚴格執行接觸傳播防護措施,加強員工及病人手部衞生。醫管局會繼續密切留意本地及不同地區的耳念珠菌流行情況,有需要時會調整公立醫院的感染控制措施及加強相關檢測,以減低傳播風險。
美國半數州份失陷
另外,美國疾病控制及預防中心本月20日在《內科醫學年鑒》發表研究指出,在2021年共通報1474宗耳念珠菌病例,比2019年的476宗,病例兩年間激增兩倍,認為是「戲劇性增長」。現時全美半數州份都有耳念珠菌病例,美國疾控中心另有數據顯示,美國各地去年共通報2377宗耳念珠菌病例,病例數再次大幅上升。
美國疾控中心指,近年的新冠疫情可能導致耳念珠菌傳播加劇,由於醫護人員多集中應付新冠病毒,對耳念珠菌檢查的重視因此降低。此外,耳念珠菌通常依附在護士袍、手套與其他個人防護裝備。由於新冠疫情下這些醫療裝備因短缺問題被迫重複使用,導致耳念珠菌有機可乘。美國疾控中心資料顯示,耳念珠菌是少數能侵入人類血液、心臟、腦部等重要器官的真菌,感染後的死亡率高達3成至6成,近半感染者90天內身亡。
對抗真菌藥有耐藥性 可在醫療設施中傳播
耳念珠菌是一種新出現的多重耐藥性真菌,為念珠菌的一種,能造成高死亡率的嚴重感染。2009年首次在日本一名病人的外耳道分泌發現。耳念珠菌對大多數抗真菌藥有耐藥性,令治療相對困難。經直接或間接接觸傳播的耳念珠菌可寄存在人體各處,包括皮膚、陰道和呼吸道,能在環境中存活數周,並能在醫療設施中引起爆發。
身上插醫療儀器 病人較易中招
長期住院的病人、身上有入侵性醫療儀器如中央靜脈導管或呼吸機的病人、糖尿病患者、免疫力受損的病人、近期曾接受大手術的病人、正服用寬廣譜抗生素或抗真菌素的人士等較易受感染。
入侵性感染 死亡率達六成
當人們接觸到耳念珠菌,若只是停留在皮膚表面的話,一般都不會引發感染或出現病徵。但如果皮膚上有傷口或者身上連接導管,例如尿喉、中心靜脈導管或其他入侵性醫療用具,耳念珠菌就有機會進入血液,引起入侵性感染,會出現頭暈、發燒、血壓偏低等病徵,免疫力較差人士甚至可能引致敗血症。美國疾病控制及預防中心數據顯示,耳念珠菌入侵性感染,死亡率高達30%至60%。

(來源:大公報A2:要聞 2023/03/26)






















































